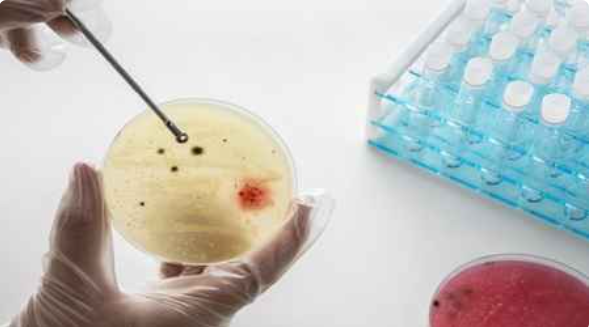

Dehradun: In a significant step towards affordable healthcare, pandemic preparedness, and indigenous biotechnology innovation, the Indian Institute of Technology Roorkee (IIT Roorkee) has developed a next-generation antibody discovery platform with the potential to transform diagnostics and therapeutics for diseases of national and global importance.
The breakthrough research, led by scientists at IIT Roorkee, involves the development of an ultra-large, high-diversity single-domain antibody (nanobody) library. The platform enables rapid identification of highly stable and high-affinity antibodies against a wide range of targets, including infectious diseases, cancer, autoimmune disorders, and emerging pathogens. By significantly reducing discovery timelines, the innovation addresses a critical gap in healthcare response, particularly during public health emergencies.
“This work reflects IIT Roorkee’s commitment to science that directly serves society,” said Prof. Rajesh Kumar, Department of Biosciences and Bioengineering, IIT Roorkee. “By developing a universal, high-diversity antibody discovery system within India, we are strengthening national capabilities for faster disease response and accelerating the development of affordable diagnostics and therapeutics for populations that need them the most.”
The research aligns strongly with the United Nations Sustainable Development Goals, particularly SDG 3 (Good Health and Well-Being), SDG 9 (Industry, Innovation and Infrastructure), and SDG 17 (Partnerships for the Goals). It is especially relevant for low- and middle-income countries, where access to timely and cost-effective healthcare solutions remains a persistent challenge.
The initiative also supports key Government of India priorities, including Atmanirbhar Bharat and Make in India, by strengthening indigenous research capabilities, generating intellectual property, and reducing reliance on imported biologics. It complements national efforts to promote translational research, enhance pandemic preparedness, and build long-term healthcare resilience.
Highlighting the broader institutional and policy relevance, Prof. K. K. Pant, Director, IIT Roorkee, stated, “This development demonstrates how fundamental research, combined with translational intent and industry collaboration, can address pressing societal challenges. IIT Roorkee remains committed to advancing solutions that strengthen India’s position as a global hub for responsible and impactful healthcare innovation.”
To accelerate real-world deployment, IIT Roorkee has entered into a strategic industry–academia collaboration to support technology transfer, scale-up, and validation of antibody-based solutions. As part of this effort, the Institute has signed a Memorandum of Understanding (MoU) with IMGENEX India Private Limited to promote collaborative research, co-development of advanced biologics, and capacity building in areas such as antibody engineering, diagnostics, therapeutics, and bioprocess development.
From the industry perspective, a senior representative of IMGENEX India Private Limited said, “This collaboration with IIT Roorkee brings together complementary strengths in academic research and industrial development, with the shared objective of translating next-generation antibody technologies into scalable and affordable healthcare solutions.”
Established in 1847, IIT Roorkee is one of India’s oldest institutions of national importance and is globally recognised for excellence in education, research, and innovation.






